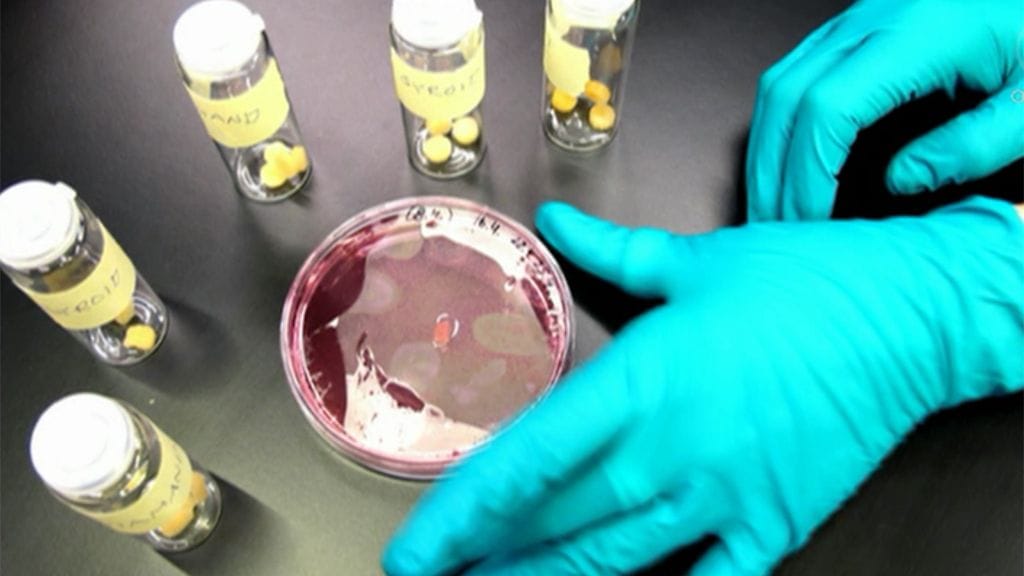

Viime syksynä hollantilaisen Marc Postin tutkimusryhmä esitteli tulevaisuuden pihvin. Nyt myös Suomessa kasvatellaan laboratoriossa solupihvejä.
Laboratoriomestari Marika Hellman Aalto-yliopistosta kasvattaa Espoon Otaniemessä solupihviä. Hellman ei kuitenkaan kaavaile uraa uuden ajan lihafarmarina, vaan kyse on yliopiston kurssista.
- Kurssilla opiskelijoille halutaan näyttää, mitä kasvatukseen kuuluu ja minkälaisia asioita siinä pitää ottaa huomioon, Hellman kertoo MTV:n Huomenta Suomessa.
Hellmanin mukaan hänen kasvattamansa pihvi on periaatteessa syötävä, vaikkei sitä sellaiseksi ole tarkoitettukaan. Kyseessä on hiiripihvi eli hiiren lihassolusta kasvatettu pihvi.
Pikkuriikkisen lihapalan kasvattamiseen kului aikaa 3-4 viikkoa.
Keinoliha on epäilemättä tulevaisuutta, mutta onko sen tuotannolle tarvetta?
Helsingin yliopiston Eläinten hyvinvointikeskuksen johtaja Satu Raussi pitää kehitystä perusteltuna.
- Jos asiaa tarkastellaan tuotantoeläinten hyvinvoinnin näkökulmasta, keinolihan tulo markkinoille voisi parantaa tilannetta, jos se korvaisi oikean eläimen lihaa, Raussi arvioi.
Raussin mukaan eläinten hyvinvointi ei toteudu täysin nykymuotoisessa eläintuotannossa.